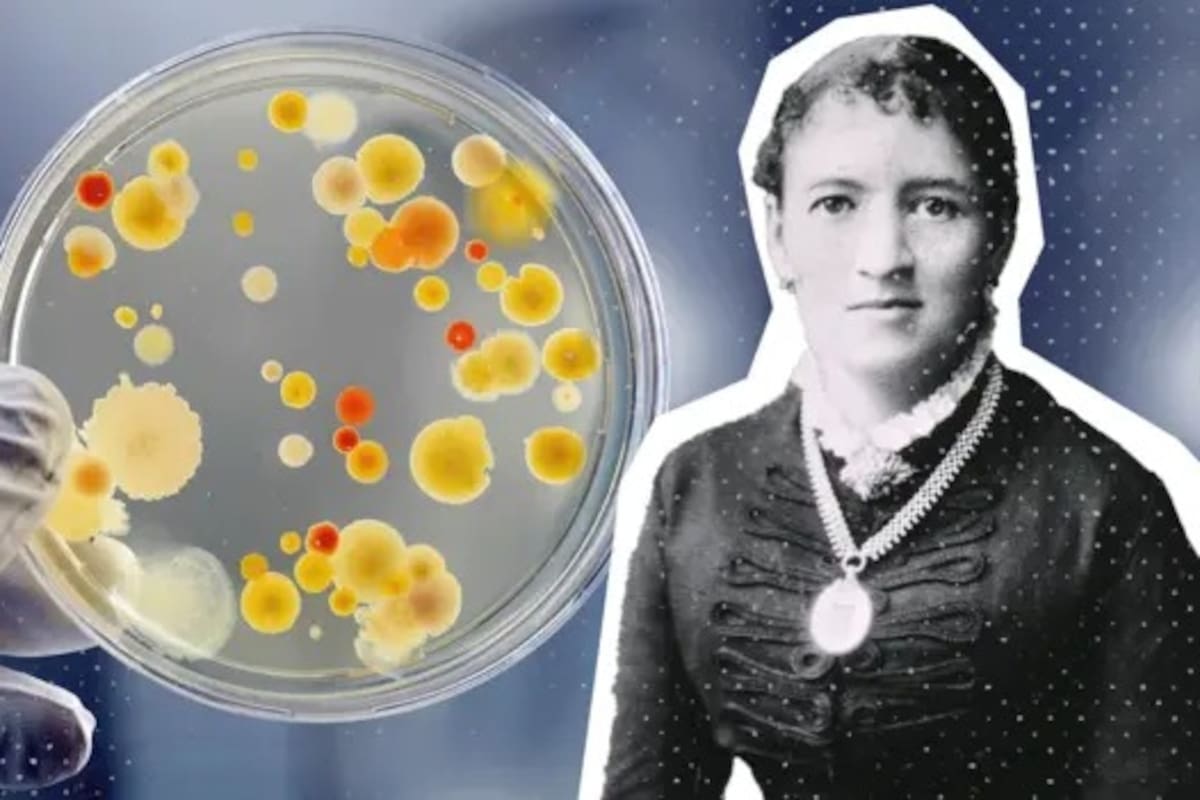
Fanny Angelina Hesse, una mujer de la que pocos –incluidos muchos microbiólogos- oyeron hablar

Se trata de Fanny Angelina Hesse, quien tuvo un papel crucial en una serie de investigaciones que llevó adelante con su marido, Walther Hesse
6 minutos de lectura'
El agar (llamado a veces agar-agar) es un ingrediente común en la comida asiática. Mezclado con agua caliente, es ideal para espesar sopas, darle estructura a los postres y, sobre todo, evitar que pierdan su forma cuando suben las temperaturas. Sin embargo, lejos del mundo culinario, esta sustancia que se obtiene de las algas marinas tiene un rol fundamental en la ciencia: es el medio estándar en el que se cultivan hongos y bacterias en el laboratorio.
Como tiene una estructura semisólida, las bacterias pueden crecer por encima de forma controlada. Así, en una placa de petri con agar (el recipiente de vidrio usado para estudiar microorganismos en el laboratorio), se pueden desarrollar distintas colonias bacterianas: pequeños grupos individuales de bacterias contenidos en un mismo espacio.
A simple vista, puede parecer un tecnicismo, pero, según le explica a BBC Mundo la doctora Vanesa Ayala-Nunez, investigadora de los Laboratorios Federales Suizos de Ciencia y Tecnología de Materiales (Empa), “esto es una maravilla, porque al controlar su crecimiento, las podés aislar”. Y este es un paso crítico tanto para estudiar y entender cómo funciona una infección, así como para llegar a un diagnóstico: identificar qué bacteria es la que está causando la enfermedad es el primer paso en la búsqueda de un tratamiento.

¿Cómo saltó este ingrediente básico de la cocina asiática a los laboratorios hace cerca de 140 años? Fue gracias a Fanny Angelina Hesse, una mujer de la que pocos –incluidos muchos microbiólogos- oyeron hablar.
Trabajo en equipo
Nacida en 1850 en Nueva York de padres inmigrantes, Lina, como la llamaba su familia, se casó con Walther Hesse, un médico alemán a quien conoció en Nueva York, que investigaba una desconocida enfermedad pulmonar que afligía a los trabajadores de las minas de uranio y que luego se descubrió era cáncer.
La pareja se trasladó eventualmente a Berlín, donde Hesse comenzó a trabajar en el laboratorio de Robert Koch (conocido más adelante como el padre de la microbiología y ganador del Nobel de Fisiología y Medicina en 1905 por identificar el bacilo que producía la tuberculosis).
Aunque Walther era el “científico oficial” en la familia, Lina y su marido trabajaban, codo a codo en el laboratorio. “Además de sus deberes en el hogar y en la educación de sus tres hijos, ella estaba muy familiarizada con el trabajo científico de Walther y lo ayudaba como si fuera una asistente técnica actual”, escribió el nieto de la pareja, Wolfgang Hesse, en una breve biografía en 1992.

Lina no era científica en estricto rigor, pero “tenía una mente científica”, le explica a BBC Mundo Corrado Nai, doctor en microbiología con años de experiencia en el uso de agar. “No podía serlo por la época y por su rol (era un ama de casa alemana), pero eran un equipo de trabajo”.
“Trabajaban juntos y el marido publicaba con su nombre, porque esa era la norma. Pero, ella tenía un papel crucial en los resultados de su marido. Lina preservaba sus registros y hacía ilustraciones científicas”, dice Nai, quien actualmente participa en la elaboración de una novela gráfica sobre la vida de Lina Hesse.
“Estas ilustraciones muestran cómo crece un organismo, cómo se ve, qué forma tiene. Y esto es parte del proceso de identificación de un microorganismo”, agrega Ayala-Nunez. Y fue trabajando juntos en el laboratorio de Koch, un día de verano 1881, después de muchos experimentos fallidos, cuando surgió la idea de probar el agar como medio de cultivo.
De la cocina al laboratorio
Para investigar la contaminación microbiana en el aire, Walther utilizaba gelatina, uno de los medios de cultivo comunes en esa época, además de la clara de huevo, el suero, la carne, rodajas de papa y otros alimentos.
Pero, una y otra vez, las bacterias degradaban la gelatina y el calor acababa derritiendo sus experimentos. Mantenerlos en frío no era una solución: dado que el objetivo era estudiar bacterias que podrían producir una enfermedad en el cuerpo, era menester reproducir en el laboratorio la temperatura fisiológica del cuerpo humano.

Y a Lina, entonces, se le ocurrió probar el agar, un ingrediente típico de la cocina tradicional de Java (excolonia neerlandesa, actualmente Indonesia) que acostumbraba usar desde hace años en la elaboración de postres y otros platos con vegetales.
Conocía en parte los secretos del agar y la cocina indonesia porque era mitad neerlandesa y porque tenía amigos en la familia que habían inmigrado a EE.UU. desde la excolonia. Sabía que, gracias al agar, los postres mantenían su estructura intacta más allá del calor que hiciera.
No se sabe con exactitud si fue Walther quien le preguntó a Lina cómo hacía para que sus postres se mantuvieran firmes en altas temperaturas o si fue Lina quien le sugirió reemplazar la gelatina con el agar. Pero, definitivamente, “ella era la que sabía sobre el agar, ella fue la responsable de esta idea”, señala Nai.

Carta a Koch
La pareja puso a prueba el agar, descubrió sus ventajas y le comunicó la noticia inmediatamente a Koch, que en ese momento estaba centrado en su investigación sobre la tuberculosis, la principal causa de muerte en los países industrializados en el siglo XIX y principios del XX.
Koch demostró en 1882 que la tuberculosis era provocada por una bacteria, lo cual abrió el camino a su diagnóstico y tratamiento. Y aunque ese mismo año mencionó en una conferencia el papel que jugó el agar en el descubrimiento del Mycobacterium tuberculosis, no incluyó ni el nombre de Lina ni el del Walther Hesse. “Esta fue la primera vez que el agar-agar apareció en la literatura científica”, comenta Nai.

Pero, el microbiólogo no cree que obviar a los Hesse haya sido una suerte de “mal comportamiento científico”, sino que se debe en parte a que Koch no había reconocido aún lo importante que era este medio de cultivo. “En el mismo texto dice que, en su opinión, el agar no funciona tan bien como el suero de la sangre”, señala Nai. Fue un proceso gradual hasta que se reconoció el valor del agar en el laboratorio.
Además, Walther no publicó ningún estudio sobre el agar, y ni él ni Lina intentaron patentar su descubrimiento. “Los Hesse nunca recibieron ninguna recompensa económica por su ‘invención’, ni siquiera se plantearon explotar el asunto comercialmente. No hubiera sido apropiado”, escribe Wolfgang en la biografía de sus abuelos.
“Ellos no buscaron que se reconociera. Simplemente, lo tomaron como una forma de solucionar una situación técnica que era muy importante”, sostiene Ayala-Nunez. “Y es que a veces, en el laboratorio, cuando es algo es técnico, se minimiza mucho, pero la verdad es que sin esa parte, no existe la ciencia”, enfatiza la investigadora.
Hoy día, el agar –un producto además barato y sencillo de preparar– es un elemento básico en todos los laboratorios de microbiología. E incluso, como lo demuestra la competencia anual de la Sociedad Estadounidense de Microbiología, hay quienes hacen arte con él.
*Por Laura Plitt
Otras noticias de BBC MUNDO
"Credenciales falsificadas". Un piloto de Air Canada voló durante 17 años sin la licencia adecuada
"Quería contribuir". Murió el doctor australiano que fue pionero en el tratamiento de su propio tumor cerebral
Según especialistas. Quiénes son Roberto Sánchez y Keiko Fujimori y qué puede decidir la carrera por presidir el inestable Perú
1“¿Dónde está el hambre?”: con los restos de una vaca carneada al hombro, un productor irrumpió en un municipio para denunciar un delito
2IRSA desembarca en Mar del Plata, con la compra del histórico shopping Los Gallegos
3Rolex, Hermès y caballos: los lujos no declarados del extitular de Arsat y su familia
- 4
El duro diagnóstico de Ricardo Darín tras el femicidio de Agostina Vega y su opinión sobre el gobierno de Javier Milei









